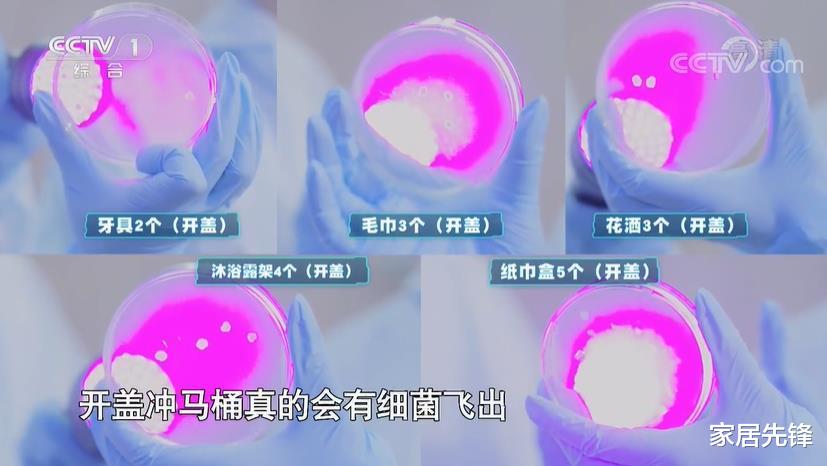

想问大家一个问题,大家平时上完厕所以后,会将马桶盖放下来吗?相信很多人面对这个问题都不知道该怎么回答。

觉得这是一件小事,根本就没放在心上,有时候放下来,有的时候就打开了。

直到有一次,看到央视曾经一档科普节目真是让我大吃一惊,原来这个马桶盖究竟是盖上还是打开,讲究竟然这么多,我一直都做错了。

上完厕所,要不要盖上马桶盖?
其实对于这个问题,不同的人就有不同的做法,很多人觉得马桶盖不关会更好,这样方便通风,异味能更快的散发出来,而且下次使用的时候更加方便,不用反复的开关马桶盖。

但有的人却认为最好还是将马桶的盖子盖上更好,这样可以隔绝臭味,也避免细菌散发出来。

我不知道大家有没有注意到,我们在按下冲水键的瞬间,马桶里面的水就会"唰"的往下流,这个时候可能会带起很多水花,我们又刚刚上完厕所,不管是大便还是小便,这些脏东西可能都会溅出来。

很多的粪便,还有细菌,就会使得水流,还有气流喷溅数十米,溅到卫生间的牙刷,毛巾,还有漱口杯上。

央视节目也给了科普,在400倍的显微镜镜头下,我们在按下马桶键的瞬间会有很多细小的液体飞溅出来,遍布了卫生间的各个角落。
马桶水箱中存储的水量有限,再加上马桶内壁的细菌繁殖,每次在冲洗马桶后,可能会有上千万种细菌同时释放,这些细菌如果没有清理干净,就会在我们家中空气流传,附着在卫生间的各个角落。

大家可以想象一下,擦脸的毛巾,刷牙的牙刷上,如果沾染了这些细菌和粪便,会不会觉得非常恶心呢?

本来卫生间的空气就很潮湿,又不通风,自然而然就成为了细菌滋生的温床。所以建议大家,我们在冲水的时候,一定要将马桶盖盖上,这是阻断细菌空气传播的第1道物理屏障。

那马桶不用的时候也有一直关着吗?
很多人觉得,那我们平时上完厕所以后冲马桶的时候可以将盖子盖上,等离开了,我们再将盖子打开就可以了。

但我劝大家,马桶在不用的时候,盖子最好还是要盖上,这是为了防止细菌。还有病毒扩散,就算是不冲水,马桶内壁还有水封,里面仍有微生物。

如果将马桶的盖子盖上,就可以有效的阻隔这些微生物随着空气流动扩散到卫生间的各个区域。

再加上卫生间的主要异味来源就是马桶,只要盖上盖子,也算是隔绝了异味,能够大大改善卫生间的空气质量,特别是没有窗户的卫生间,效果会更加明显。

如果家里面有小孩或者宠物的家庭,那真的太重要了,马桶盖如果开着的话,孩子还有宠物都很可能到里面玩水,更加容易传播疾病。

尤其是牙刷,首饰,还有各种各样的小物件,都很容易不小心掉进去,但是把马桶盖关上,就不会有这些忧虑了。

看完这篇文章,相信大家就明白了,正确的做法就是将马桶盖子盖上,然后按下冲水键,这样可以避免在冲水的时候气旋将细菌带出去。

另外,我们在冲水以后,可以留意一下马桶内壁,如果有污垢没冲干净的话,一定要及时再次冲洗,不然残留的污染物会很快滋生细菌,还会产生难闻的异味,后续清洁起来也很麻烦。

小结:
很多人都没想到,一个简单盖马桶盖的动作竟然危害这么大,从现在起,大家就要赶紧养成盖上马桶盖冲水的习惯,同时还要定期清理卫生间,保持卫生间的干净卫生。